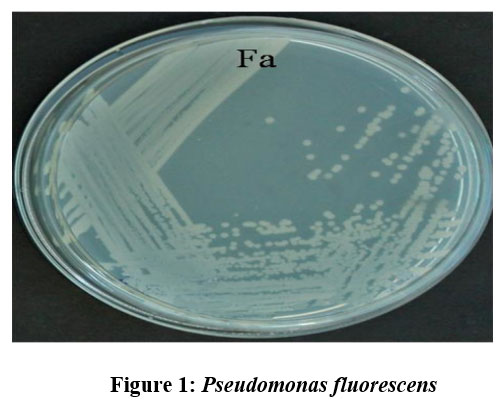

#phytopathogen 搜尋結果
Recently I requested a new chicory leaf icon on @BioRender, and they did it! Thank you, it will be helpful for #phytopathogen researchers 👍🏻

Some bad news from Corsica: Xylella fastidiosa has been detected in our Olive trees. Avemu dà pruteghja l'alivu Corsu baraglia @Corse_Matin @UnivCorse @SRiolacci #xylella #fastidiosa #phytopathogen

#filamentous #phage against #phytopathogen #Erwinia as #biocontrol #agent to #combat #fireblight #Publication @Micro_MDPI bit.ly/38uUHUm #Tunisia #University #Sfax & @leuvenresearch #IPM #crop #protection #microbiology #pear #bacteria #virus #genome #DNA #bioassay

Our study highlights Conidial fusion as an alternative mechanism for generation of pheno-genotypic diversity in fungi rdcu.be/chS0j kudos @Nikita_myco2312 @ari_pune @serbonline @IndiaDST @KaustuvSanyal #fungi #phytopathogen #quorumsensing

Phytopathogen-induced changes to plant methylomes link.springer.com/article/10.100… #plantscience #Phytopathogen #methylomes @PlantCellRep ♻️

Good Rhodococcus, bad Rhodococcus: From beneficial symbiont to #phytopathogen, all it takes is one virulence plasmid: elifesciences.org/articles/30925 via @eLife #PistachioBushyTopSyndrome #Epidemiology

🍄 🚨 New Publication Alert 🚨 🧬 Explore the latest advancements in #phytopathogen #GenomeSequencing and annotation techniques in this insightful #review 🌿 🌾 bit.ly/3ZqUyJI

🌱🌿 The images we are sharing with you come all the way from Peru, thanks to our distributor in the country, @inkagro @InkagroP Specifically, these images are about a trial for the control of a #phytopathogen and #nematodes.

Pr-favoured variants of the bacteriophytochrome from the plant pathogen Xanthomonas campestris hint on light regulation of virulence-associated mechanisms buff.ly/3nghHMB By Florencia Malamud, Hernán Ruy Bonomi and colleagues @CONICETDialoga #Phytochrome #Phytopathogen

Antibiotic Sensitivity of Some Phytopathogen Bacteria of Genus Pseudomonas Isolated from Fruit Trees of Azerbaijan - By Kh.G. Ganbarov DOI: dx.doi.org/10.20431/2349-… International Journal of Research Studies in Biosciences #Biosciences #Phytopathogen #Bacteria #FruitTrees

🔝📢 Editor's Choice Article in JoF -> "The #Fungal Protein Mes1 Is Required for Morphogenesis and Virulence in the Dimorphic #Phytopathogen #𝘜𝘴𝘵𝘪𝘭𝘢𝘨𝘰 𝘮𝘢𝘺𝘥𝘪𝘴" 🔎👉 Discover more here: mdpi.com/2309-608X/8/8/…

#Bacterial quorum sensing response enables the vascular #phytopathogen #Xanthomonas campestris to escape host vasculature & progressively invade and localize #parenchymal #chloroplasts, this in turn triggers host chlorophagy & systemic infection bit.ly/3xhXxEL

Phytophthora infestans has 7 genes coding for Glucokinase!! Glk-1 is one of the most expressed during the establishment of the infection and is very versatile. I invite you to read this article. #Phytopathogen #Glucokinase #Science #biochemistry

Defense-related anti-oxidative response is a vital defense mechanism of #plants against pathogen. #Ralstonia solanacearum is an important #phytopathogen. This study evaluated the defense response of #patchouli inoculated with virulent R. #solanacearum.bit.ly/2QpGxqF


The #Phytopathogen #Fusarium verticillioides Modifies the Intestinal Morphology of the Sugarcane Borer ✏️by Diego Z. Gallan et al. 👉Full-Text mdpi.com/2076-0817/12/3… #insectfungusinteractions

#EVs from the #hemibiotrophic #phytopathogen #Colletotrichum higginsianum include proteins involved in vesicle transport, cell wall biogenesis and the synthesis of secondary metabolites #fungi #fungal #pathogen #proteomics biorxiv.org/content/10.110… @INRAE_Bioger @Brian_DM_Rutter

🥳#mdpiagriculture New Paper "Secondary Metabolites Produced by Neofusicoccum Species Associated with Plants: A Review" by Maria Michela Salvatore et al. #phytopathogen #metabolite 👉Welcome to read: mdpi.com/2077-0472/11/2…

Identification of Ulmus Pumila L. Pathogens with the Help of PCR biotech-asia.org/?p=5291> #Phytopathogen #InvasiveBlastsandDiseases #UlmusPumila #Toxicity #Micromycetes #antagonists #PCR #Nanoparticles #Science #NanoScience #technology #Biology #Bioengineering

Alfalfa Mosaic Virus is a #phytopathogen that infect your #cannabis plants through #aphids. For #AMV preventative measures 🔗vernebio.com/pests-that-car… #vernebio #cannabiscultivation #agriculture #plants #biotech #CannabisNews #biology #Alfamovirus #disease #pest #crops #article

Discovery of Anomer-Inverting Transglycosylase: Cyclic Glucohexadecaose-Producing Enzyme from Xanthomonas, a Phytopathogen | Journal of the American Chemical Society @TUS_PR_en #Anomer #Transglycosylase #Phytopathogen #Xanthomonas #Enzyme pubs.acs.org/doi/10.1021/ja…
🔝📢 Editor's Choice Article in JoF -> "The #Fungal Protein Mes1 Is Required for Morphogenesis and Virulence in the Dimorphic #Phytopathogen #𝘜𝘴𝘵𝘪𝘭𝘢𝘨𝘰 𝘮𝘢𝘺𝘥𝘪𝘴" 🔎👉 Discover more here: mdpi.com/2309-608X/8/8/…

bit.ly/3RYijXN - Read the Article here Biological Control for Solanum melongena L. in Sustainable Agriculture. #Bioagent #PGPR #Phytopathogen #Phytostumillatoryeffect #Sodiumalginate #Agriculture #climatechange #AgriculturalSciences #agtech #Agronomy #PlantBreeding

bit.ly/3RYijXN - Read the Article here Biological Control for Solanum melongena L. in Sustainable Agriculture. #Bioagent #PGPR #Phytopathogen #Phytostumillatoryeffect #Sodiumalginate #Agriculture #climatechange #AgriculturalSciences #agtech #Agronomy #PlantBreeding
🍄 🚨 New Publication Alert 🚨 🧬 Explore the latest advancements in #phytopathogen #GenomeSequencing and annotation techniques in this insightful #review 🌿 🌾 bit.ly/3ZqUyJI

🌱🌿 The images we are sharing with you come all the way from Peru, thanks to our distributor in the country, @inkagro @InkagroP Specifically, these images are about a trial for the control of a #phytopathogen and #nematodes.

📢 Characterization of Pseudofusicoccum Species from Diseased Plantation-Grown Acacia mangium, Eucalyptus spp., and Pinus massoniana in Southern China 👨🎓 by Guoqing Li et al. 🔗 mdpi.com/2076-0817/12/4… 👉 Special Issue: Plant Pathogenic #Fungi #plantpathogen #phytopathogen

#plantpathogen #phytopathogen #plantimmunity I just joined Kudos, they are featuring our PLoS Pathogen paper. This gives a lay summary. link.growkudos.com/1t177pn8w74
The #Phytopathogen #Fusarium verticillioides Modifies the Intestinal Morphology of the Sugarcane Borer ✏️by Diego Z. Gallan et al. 👉Full-Text mdpi.com/2076-0817/12/3… #insectfungusinteractions

#filamentous #phage against #phytopathogen #Erwinia as #biocontrol #agent to #combat #fireblight #Publication @Micro_MDPI bit.ly/38uUHUm #Tunisia #University #Sfax & @leuvenresearch #IPM #crop #protection #microbiology #pear #bacteria #virus #genome #DNA #bioassay

Phytopathogen-induced changes to plant methylomes link.springer.com/article/10.100… #plantscience #Phytopathogen #methylomes @PlantCellRep ♻️

Good Rhodococcus, bad Rhodococcus: From beneficial symbiont to #phytopathogen, all it takes is one virulence plasmid: elifesciences.org/articles/30925 via @eLife #PistachioBushyTopSyndrome #Epidemiology

Some bad news from Corsica: Xylella fastidiosa has been detected in our Olive trees. Avemu dà pruteghja l'alivu Corsu baraglia @Corse_Matin @UnivCorse @SRiolacci #xylella #fastidiosa #phytopathogen

🍄 🚨 New Publication Alert 🚨 🧬 Explore the latest advancements in #phytopathogen #GenomeSequencing and annotation techniques in this insightful #review 🌿 🌾 bit.ly/3ZqUyJI

Recently I requested a new chicory leaf icon on @BioRender, and they did it! Thank you, it will be helpful for #phytopathogen researchers 👍🏻

Our study highlights Conidial fusion as an alternative mechanism for generation of pheno-genotypic diversity in fungi rdcu.be/chS0j kudos @Nikita_myco2312 @ari_pune @serbonline @IndiaDST @KaustuvSanyal #fungi #phytopathogen #quorumsensing

Pr-favoured variants of the bacteriophytochrome from the plant pathogen Xanthomonas campestris hint on light regulation of virulence-associated mechanisms buff.ly/3nghHMB By Florencia Malamud, Hernán Ruy Bonomi and colleagues @CONICETDialoga #Phytochrome #Phytopathogen

#EVs from the #hemibiotrophic #phytopathogen #Colletotrichum higginsianum include proteins involved in vesicle transport, cell wall biogenesis and the synthesis of secondary metabolites #fungi #fungal #pathogen #proteomics biorxiv.org/content/10.110… @INRAE_Bioger @Brian_DM_Rutter

#Bacterial quorum sensing response enables the vascular #phytopathogen #Xanthomonas campestris to escape host vasculature & progressively invade and localize #parenchymal #chloroplasts, this in turn triggers host chlorophagy & systemic infection bit.ly/3xhXxEL

Antibiotic Sensitivity of Some Phytopathogen Bacteria of Genus Pseudomonas Isolated from Fruit Trees of Azerbaijan - By Kh.G. Ganbarov DOI: dx.doi.org/10.20431/2349-… International Journal of Research Studies in Biosciences #Biosciences #Phytopathogen #Bacteria #FruitTrees

🔝📢 Editor's Choice Article in JoF -> "The #Fungal Protein Mes1 Is Required for Morphogenesis and Virulence in the Dimorphic #Phytopathogen #𝘜𝘴𝘵𝘪𝘭𝘢𝘨𝘰 𝘮𝘢𝘺𝘥𝘪𝘴" 🔎👉 Discover more here: mdpi.com/2309-608X/8/8/…

The #Phytopathogen #Fusarium verticillioides Modifies the Intestinal Morphology of the Sugarcane Borer ✏️by Diego Z. Gallan et al. 👉Full-Text mdpi.com/2076-0817/12/3… #insectfungusinteractions

Defense-related anti-oxidative response is a vital defense mechanism of #plants against pathogen. #Ralstonia solanacearum is an important #phytopathogen. This study evaluated the defense response of #patchouli inoculated with virulent R. #solanacearum.bit.ly/2QpGxqF


#EditorsChoice A Siderophore Analog of Fimsbactin from #Acinetobacter Hinders Growth of the #Phytopathogen #Pseudomonassyringae and Induces Systemic Priming of #Immunity in Arabidopsis thaliana, by Fabrice Betoudji et al. 👉👉Full-Text mdpi.com/2076-0817/9/10…

🥳#mdpiagriculture New Paper "Secondary Metabolites Produced by Neofusicoccum Species Associated with Plants: A Review" by Maria Michela Salvatore et al. #phytopathogen #metabolite 👉Welcome to read: mdpi.com/2077-0472/11/2…

📢 Characterization of Pseudofusicoccum Species from Diseased Plantation-Grown Acacia mangium, Eucalyptus spp., and Pinus massoniana in Southern China 👨🎓 by Guoqing Li et al. 🔗 mdpi.com/2076-0817/12/4… 👉 Special Issue: Plant Pathogenic #Fungi #plantpathogen #phytopathogen

🌱🌿 The images we are sharing with you come all the way from Peru, thanks to our distributor in the country, @inkagro @InkagroP Specifically, these images are about a trial for the control of a #phytopathogen and #nematodes.

bit.ly/3RYijXN - Read the Article here Biological Control for Solanum melongena L. in Sustainable Agriculture. #Bioagent #PGPR #Phytopathogen #Phytostumillatoryeffect #Sodiumalginate #Agriculture #climatechange #AgriculturalSciences #agtech #Agronomy #PlantBreeding

Identification of Ulmus Pumila L. Pathogens with the Help of PCR biotech-asia.org/?p=5291> #Phytopathogen #InvasiveBlastsandDiseases #UlmusPumila #Toxicity #Micromycetes #antagonists #PCR #Nanoparticles #Science #NanoScience #technology #Biology #Bioengineering

Something went wrong.
Something went wrong.
United States Trends
- 1. Discussing Web3 N/A
- 2. Good Sunday 41.5K posts
- 3. Auburn 46.5K posts
- 4. At GiveRep N/A
- 5. MACROHARD 6,812 posts
- 6. Brewers 66.2K posts
- 7. #SEVENTEEN_NEW_IN_TACOMA 36.7K posts
- 8. Gilligan's Island 5,019 posts
- 9. Wordle 1,576 X N/A
- 10. Georgia 67.8K posts
- 11. Utah 25.3K posts
- 12. #MakeOffer 19.4K posts
- 13. Cubs 56.9K posts
- 14. #SVT_TOUR_NEW_ 28.9K posts
- 15. Kirby 24.3K posts
- 16. #HawaiiFB N/A
- 17. QUICK TRADE 2,335 posts
- 18. #BYUFOOTBALL 1,027 posts
- 19. mingyu 103K posts
- 20. Holy War 2,083 posts